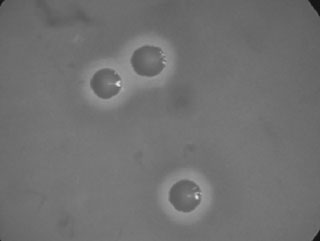

Arch. Med. Vet. 37, Nº 2, 2005, págs. 161-67
COMUNICACION
Linfoadenitis Caseosa (LAC) en ovinos en la XI Región, Chile#
Caseous Lymphadenitis (CLA) in sheep at the XI Region of Chile
N Tadich1*, C Alvarez1, T Chacón2 , H Godoy2
1 Instituto de Ciencias Clínicas
Veterinarias, Fac. de Ciencias Veterinarias, Universidad Austral de Chile.
2 Fundación para
el Desarrollo Regional de Aysén (FUNDA), Coyhaique.
SUMMARY
The aim of this study was to determine the presence of Caseous Lymphadenitis (CLA) in sheep of the XI Region, Chile. The survey was carried out at the INDUCAR abattoir of Coyhaique, XI Region, Chile, during August and November 2002. A total of 1,397 sheep of different categories (lambs, hogget, ewes, wether and rams) from different sources and ages were examined. Age was estimated based on dental chronometry. Hot carcasses were examined by visual inspection and all the lymph nodes were palpated. The lungs, liver and kidney were also examined. The lymph nodes and organs with CLA - like lesions were removed and material from the periphery of the abscess was collected with sterile swabs, sotred in Stuart transport medium and sent to the Institute of Microbiology, Faculty of Sciences at the University Austral of Chile. Half lymph nodes samples were also sent weekly for culture. Positive cultures to Corynebacterium pseudotuberculosis were only obtained from lesions in adult animals. From 105 samples cultured, 81 were positive. The prevalence of CLA in the adult animals was 11.6% and decreased to 5.8% when the whole examined population was considered. The frequency of presentation of CLA increased with the age of the animals. The lymph nodes more frequently affected were the superficial lymph nodes (54.3%). Individually, the most commonly affected lymph nodes were the mediastinal (35.1%), followed by the prescapular nodes (30.8%). In relationship to the origin of the affected animal, most were from the Ñirehuao and Río Cisnes sheep farms and the Balmaceda and El Claro sectors (81.5%). Based in our findings of macroscopic lesions in the affected lymph nodes and lung and their positive cultures to C. pseudotuberculosis, it can be concluded that the disease Caseous Lymphadenitis is present in the XI Region of Chile.
Palabras clave: linfoadenitis caseosa, Corynebacterium pseudotuberculosis, ovinos.
Key words: caseous lymphadenitis, Corynebacterium pseudotuberculosis, sheep.
RESUMEN
El objetivo de este estudio fue diagnosticar la presencia de Linfoadenitis Caseosa (LAC) en ovinos de la XI Región, Chile. El estudio se realizó en la Planta Faenadora de Carnes Inducar de Coyhaique, XI Región, Chile, entre los meses de agosto y noviembre del año 2002.
Se examinó un total de 1.397 ovinos de distintas categorías (corderos, borregas, ovejas, capones y carneros), edades y procedencias. La determinación de la edad se realizó mediante cronometría dentaria. El examen de las canales calientes se realizó mediante inspección y palpación de todos los nódulos linfáticos de la canal. También se examinaron el parénquima pulmonar, hígado y riñones.
Los nódulos linfáticos y órganos que presentaron lesiones similares a las producidas por LAC fueron extraídos y se obtuvieron muestras de la periferia de ellos. El material obtenido fue incorporado a medio Stuart para su transporte. Además, muestras de mitades de los nódulos también fueron enviadas semanalmente al Instituto de Microbiología, Facultad de Ciencias de la Universidad Austral de Chile.
Sólo se obtuvieron cultivos positivos a Corynebacterium pseudotuberculosis de animales adultos. De las 105 muestras enviadas para cultivo, 81 fueron positivas a LAC. La prevalencia de LAC en los animales adultos fue de un 11,6% y de un 5,8% al considerar la población total examinada. La frecuencia de presentación aumentó a medida que aumentaba la edad de los animales.
Los nódulos linfáticos más frecuentemente afectados fueron los superficiales con un 54,3%. Al considerar los nódulos individualmente, los más afectados fueron los mediastínicos con un 35,1%, seguido de los preescapulares con un 30,8 %. Con respecto a la procedencia de los animales afectados, en su mayoría correspondían a las estancias Ñirehuao y Río Cisnes, así como del sector Balmaceda y El Claro (81,5%).
En base a los hallazgos de lesiones macroscópicas de los nódulos afectados y a sus cultivos positivos a C. Pseudotu-berculosis, se concluye que la enfermedad linfoadenitis caseosa se encuentra presente en la XI Región, Chile.
INTRODUCCION
Linfoadenitis Caseosa (LAC) es una enfermedad infecciosa bacteriana crónica que afecta a ovejas y cabras, caracterizada por la inflamación supurativa necrotizante de uno o más nódulos linfáticos (Brown y Olander 1987). Afecta particularmente los nódulos linfáticos superficiales; sin embargo, puede comprometer también a órganos y nódulos linfáticos viscerales (Batey, 1986). LAC es una de las enfermedades más comunes de los ovinos en el mundo, está presente en Norte y Sudamérica, Australia, Nueva Zelanda, Europa y Sudáfrica (Brown y Olander 1987; Williamson 2001), siendo afectados ambos sexos por igual (Stoops y col 1984). Afecta generalmente a ovinos adultos, aunque Maddy (1953) observó lesiones
en corderos de aproximadamente 4 meses de edad. Paton y col (1988) sugieren que algunas razas de ovejas, como Merino, parecen ser más susceptibles que otras.C. pseudotuberculosis es el agente causante de la enfermedad, conocido también como el bacilo de Preisz - Nocard o Corynebacterium ovis (Brown y Olander 1987). Es una bacteria anaerobia facultativa, Gram positiva, sin motilidad y que no forma esporas. El organismo es excretado en las heces y permanece viable por varios meses, aún a temperaturas bajo cero; es destruido rápidamente por los rayos del sol y a temperaturas de 58°C por 10 minutos, así también con los desinfectantes de uso habitual (Maddy 1953). C. pseudotuberculosis puede sobrevivir hasta 8 meses en el suelo y en fomites de corrales como superficies de madera, paja y heno por 1, 3 y 8 semanas, respectivamente, en condiciones húmedas y frías (Augustine y Renshaw 1986).
C. pseudotuberculosis es intermitentemente expectorado por las ovejas afectadas (Paton 1997), pero la mayor contaminación del medio ambiente ocurre por la ruptura de abscesos (Batey 1986). Esto ocurre frecuentemente durante la esquila, aunque la incidencia aumenta con las subsiguientes esquilas del animal (Paton 1997).
La LAC visceral ha sido considerada una de las mayores causas de daño económico en el "Síndrome de la oveja delgada" en USA (Brown y col 1985). La enfermedad también puede producir reducción en la producción de leche, de la vida reproductiva y emaciación en ovejas adultas (Gates y col 1977). Las lesiones pulmonares pueden disminuir la capacidad respiratoria funcional, incrementando la susceptibilidad a enfermedades sistémicas (Stoops y col 1984). C. pseudotuberculosis es además una bacteria que puede afectar al hombre, habiéndose observado en personal de mataderos y en personas que están en contacto con ovejas vivas en países donde la LAC es endémica (Brown y Olander 1987).
La prevalencia de la enfermedad ha sido determinada en distintos países. En Australia, diferentes estudios muestran una prevalencia entre un 26% a un 45% (Middleton y col 1991, Paton 1997. En el Oeste de Estados Unidos se determinó una prevalencia de 42,4% (Stoops y col 1984). En Noruega, Kuria y Holstad (1989) mediante la inhibición de la beta hemólisis (BHI) obtuvieron un 8,6% de prevalencia. En Checoslovaquia, estudios serológicos establecieron una positividad de 34,7% (Literak y col 1994). En la XII región de Chile, Montiel (1995) encontró que LAC era la segunda causa más importante de decomisos con un 1,95% de animales afectados de un total de 92.432 beneficiados.
En Estados Unidos LAC es la tercera causa en importancia de pérdidas económicas en la industria ovina y en Australia está considerada entre las cinco enfermedades económicamente más importantes en la producción ovina (Williamson 2001). Paton y col (1997) determinaron que en Australia LAC origina pérdidas cercanas a los US$ 30 millones/año.
El Servicio Agrícola y Ganadero (SAG) en su Boletín de Vigilancia Epidemiológica (Chile 1996) indicó que el número de animales decomisados por LAC fue de un 1% de un total de 563.193 ovinos beneficiados, registrándose decomisos solo en los mataderos de la Región de Magallanes. En el año 1997 se faenaron 642.028 ovinos en el país y de estos el total de decomisos por causas infecciosas y parasitarias fue de 63.138, siendo la LAC la tercera causa en importancia, correspondiéndole un 14,3% del total de decomisos (Chile 1997). En Coyhaique la oficina del Servicio Agrícola y Ganadero al momento de realizar este estudio no tenía notificaciones de LAC, por lo cual la enfermedad no estaba oficialmente presente en esta Región.
En base a los antecedentes señalados se formuló la hipótesis de que la enfermedad Linfoadenitis Caseosa (LAC) estaba presente en el ganado ovino de la XI Región, Chile. El objetivo general fue diagnosticar la presencia de LAC en ovinos faenados en la Planta Faenadora de Carnes Inducar de Coyhaique, XI Región. Los objetivos específicos fueron: identificar los nódulos linfáticos afectados por LAC en el ganado ovino inspeccionado, determinar mediante cultivo la presencia del C. pseudotuberculosis en los nódulos linfáticos y órganos con lesiones macroscópicas tipo LAC, y establecer la procedencia de los animales afectados.
MATERIAL Y METODOS
El material estuvo constituido por 1.397 canales de ovinos de distintas procedencias y de diferentes edades y categorías (corderos, borregos, ovejas, carneros y capones) beneficiados en el matadero Inducar de la ciudad de Coyhaique entre agosto y noviembre del año 2002. La procedencia de los ovinos se presenta en el cuadro 1. La distribución numérica y porcentual de acuerdo a las diferentes categorías de ovinos beneficiados se presenta en el cuadro 2.
| Cuadro 1. Distribución
de los ovinos con cultivos positivos a LAC, de acuerdo al sector de
procedencia.
Distribution of sheep with positive cultures to CLA, according to the place of origin. |
||
|
|
||
| Sector de procedencia | Cantidad |
(%) |
|
|
||
| Ñirehuao | 22 | (27,2) |
| Balmaceda | 15 | (18,5) |
| Río Cisnes | 15 | (18,5) |
| El Claro | 14 | (17,3) |
| Vista Hermosa | 02 | 0(2,5) |
| Lago Atravesado | 01 | 0(1,2) |
| Puerto Aysén | 01 | 0(1,2) |
| Desconocido | 11 | (13,6) |
|
|
||
| Total | 81 | (100,0)0 |
|
|
||
| Cuadro 2. Distribución
según categoría de los ovinos examinados en el matadero
Inducar de Coyhaique.
Distribution according to category of the sheep examined at the Inducar abattoir of Coyhaique. |
||
|
|
||
| Categorías de ovinos beneficiados | Total | Porcentaje |
|
|
||
| Borregas | 572 | 40,94% |
| Ovejas | 547 | 39,16% |
| Capones | 136 | 09,74% |
| Corderos | 127 | 09,09% |
| Carneros | 015 | 01,07% |
|
|
||
| Total | 1.3970 | 100,0%0 |
|
|
||
Identificación de los animales. Los ovinos fueron identificados al llegar al matadero, registrándose según el número de loteo por feria (pintado en la espalda) y el número del abastero. Si el animal no venía de feria (sin número), se encerraba en un corral aparte. Los animales fueron ordenados por lote para su beneficio. El proceso de sacrificio se realizó mediante yugulación externa. Luego de ser desollados, eviscerados y de recibir una ducha con agua fría se les anotó el número del abastero en la canal. Posteriormente fueron dispuestos en la línea de faena, donde se realizó la inspección médico veterinaria. En este lugar se procedió a la identificación y clasificación de las canales, para luego seguir con la inspección, incluyendo cabezas y vísceras.
Identificación de las canales. Se clasificó cada animal según edad y categoría, registrándose en una planilla. A cada animal faenado se le otorgó un número correlativo, se anotó el número del abastero y número de loteo por feria. Finalmente, se indicó si el animal era sospechoso a LAC y qué nódulos se encontraban comprometidos.
La determinación de la edad se efectuó sobre la base de la cronometría dentaria (Sherman y Robinson 1983) y la categoría en 5 grupos: Cordero: del nacimiento a los 6 meses de edad; Borrego: desde los 6 meses al año de edad; Oveja: con dos dientes a boca llena; Capón (macho castrado): con dos dientes hasta boca llena; Carnero (macho entero): con dos dientes hasta boca llena.
Examen de las canales. Se realizó individualmente mediante inspección, en la cual se observó estado nutricional, nódulos linfáticos superficiales en busca de asimetrías y adherencias y por palpación, donde cada canal se palpó en forma completa, con énfasis en los nódulos linfáticos periféricos, mandibulares, parotídeos, preescapulares, prefemorales, inguinales superficiales, mamarios y poplíteos, considerando la consistencia y tamaño de ellos. Además, se revisaron los nódulos mediastínicos y traqueobronquiales. También se examinaron el parénquima pulmonar, hígado y riñones.
Recolección y envío de muestras. Todos los nódulos linfáticos abscedados y los nódulos sospechosos fueron separados de la canal evitando abrir el nódulo. Los nódulos linfáticos así recolectados se colocaron en bolsas estériles rotuladas con el número del animal y el nombre del nódulo afectado, y se almacenaron en una nevera portátil con medios refrigerantes. Posteriormente fueron llevados al Laboratorio de Diagnóstico Veterinario del SAG en Coyhaique, donde fueron abiertos en forma aséptica para verificar que correspondieran macroscópicamente con las características de LAC (figura 1).
 |
| Figura 1. Nódulo linfático
congelado mostrando los anillos concéntricos característicos
de LAC (configuración de anillo de cebolla), en un ovino con
cultivo positivo a C. pseudotuberculosis.
Frozen lymph node showing the concentric rings characteristics of CLA (onion rings), in a sheep with positive culture to C. pseudotuberculosis. |
Las primeras 21 muestras fueron enviadas en medio de transporte Stuart, de acuerdo a recomendaciones del laboratorio, para lo cual se tomó en forma aséptica material purulento de la periferia de los abscesos con una tórula estéril (Stoops y col 1984). Debido a la falta de crecimiento del material enviado en las tórulas, en los 30 casos posteriores se enviaron dos muestras por cada animal sospechoso de LAC (muestras pareadas; tórula y nódulo congelado). Finalmente, las últimas 54 muestras se enviaron como nódulos linfáticos. El absceso o la mitad de éste se colocaba en otra bolsa estéril, debidamente rotulada y se congelaba a -27º C de temperatura. Las muestras se enviaron (en cajas térmicas con ice pack), en forma semanal vía aérea para el examen bacteriológico.
Exámenes de bacteriología. Se consideró animal positivo a LAC, cuando el aislamiento en bacteriología del agente fuera positivo (figura 2). La identificación bacteriológica se llevó a cabo en el Instituto de Microbiología, Facultad de Ciencias de la Universidad Austral de Chile.
|
|
Figura 2. Colonias de C. pseudotuberculosis obtenidas de un nódulos linfático abscedado. Colonies of C. pseudotuberculosis obtained from an abscess in a lymph node. |
Análisis estadístico. Los antecedentes obtenidos se ingresaron a una planilla Excel. Para su análisis se utilizó estadística descriptiva, presentando los resultados en forma de valores totales y porcentajes.
RESULTADOS Y DISCUSION
Este estudio demostró la presencia de LAC en ovinos de la XI Región. La enfermedad no se encontraba oficialmente presente, ni registrada por las autoridades sanitarias de la XI Región, aunque el Servicio Agrícola y Ganadero reconocía informalmente su presencia. Esto demuestra problemas en el sistema de notificación de enfermedades, en especial en las estadísticas de decomisos generadas en plantas faenadoras de carnes por el Servicio de Salud, otro organismo sanitario, cuyas prioridades técnicas son distintas y en las cuales no se consignan hallazgos por esta causa.
El estudio no es representativo de todos los predios de la región, ya que más del 65% de los ovinos beneficiados provino sólo de cuatro grandes estancias. Existió un porcentaje de animales en que no se pudo determinar el predio de origen (10,45%), debido a que provenían de abasteros sin la información correspondiente en la guía de libre tránsito. Lo mismo ocurrió con varios de los predios pequeños, que corresponden a predios de acopio, donde se compran animales en feria y se llevan a matadero según necesidad. Los tres sectores con mayor presentación de LAC correspondieron a estancias grandes, siendo una de ellas la más grande la XI Región. El cuarto predio con mayor número de ovinos positivos fue un predio de acopio de animales en el sector El Claro.
De los animales examinados, 105 presentaron abscesos en los nódulos linfáticos. Los exámenes bacteriológicos indicaron que sólo 81 casos eran animales positivos a C. pseudotuberculosis, lo que corresponde a una prevalencia de 11,6% de la población adulta beneficiada y a un 5,8% de la población total. De éstos, tres casos correspondieron a muestras enviadas con tórula, y en otros 78 casos el agente fue identificado a partir de los nódulos linfáticos enviados a laboratorio. Esta prevalencia de LAC es superior a la informada por Montiel (1995) en Magallanes. Esto se debe a la distribución de las categorías examinadas, ya que en el estudio de Montiel (1995) el 88% de los animales correspondían a animales jóvenes (corderos y borregos). Estos porcentajes también son superiores a los decomisos por LAC informados por el Servicio Agrícola y Ganadero en los mataderos de la Región de Magallanes durante el año 1996 (Chile 1996) y el año 1997 (Chile 1997).
El porcentaje de positividad, en este estudio, es inferior al obtenido en Australia por Paton (1997) con un 45% de prevalencia en un total de 412 rebaños ovinos, o al reportado en Noruega por Kuria y Holstad (1989) con un 8,6% de prevalencia mediante diagnóstico serológico.
La distribución de las categorías de edad de los animales beneficiados (cuadro 3) obedece a las características normales de manejo y producción en Aysén, en donde en la época primaveral se produce el mayor beneficio de borregas y gran parte de las ovejas de rechazo en las explotaciones ovinas de la zona. Los mayores porcentajes de presentación de la enfermedad se encontraron en aquellos animales con seis dientes (13,04%) y boca llena (12,95%) (cuadro 3). El que sólo se hayan encontrado animales adultos positivos, aumentando la frecuencia de presentación con el aumento de la edad, se debe a que LAC es una enfermedad de curso crónico cuya presentación aumenta con la exposición repetida a C. pseudotuberculosis en el medio ambiente y durante las esquilas del animal (Paton y col 1995).
Se han realizado estudios en animales adultos en distintos países con porcentajes que van de un 26% a un 50,4%, superiores al 11,6% encontrado en este trabajo (Sheikh-Omar y Shah 1984, Stoops y col 1984, Middleton y col 1991). Esto podría explicarse, en parte, por el hecho de que existe un porcentaje de lesiones que por su tamaño pueden no ser detectadas en la inspección de rutina (Middleton y col 1991).
Algunos manejos como la esquila y baño antisárnico pueden influir en una mayor diseminación de LAC; estos manejos se incrementan con la vida del animal. Cuando existe un estrecho contacto entre los animales después de la esquila, donde permanecen 3 a 4 horas agrupados, estando cubiertos, o en potreros pequeños, protegidos del viento y de los rayos ultravioleta, se provee la oportunidad para que prosperen los aerosoles de C. pseudotuberculosis, y así éstos puedan diseminarse sobre cortes de la piel de ovejas no infectadas (Paton y col 1996). El baño antisárnico inmediatamente posterior a la esquila también aumenta el riesgo de presentar mayor número de lesiones en los nódulos linfáticos, aun en ovejas con la piel intacta; el mecanismo por el cual C. pseudotuberculosis penetra la piel en estos animales no es conocido, pero se sabe que los ovinos pierden factores protectivos presentes en la lana, por acción de los químicos utilizados. Estos químicos podrían afectar los mecanismos de defensa de la piel, permitiendo que la bacteria consiga entrar a través de ella (Paton y col 2002). El baño antisárnico es particularmente importante cuando ocurre dentro de la primera o segunda semana postesquila (Lloyd 1994).
De los 24 animales en que no se aisló C. pseudotuberculosis, 18 de las muestras enviadas habían sido obtenidas con tórula, de éstas, nueve fueron negativas, 1 positiva a E. Coli, siete a Pseudomona aeruginosa y una positiva a Pseudomona sp. Otros seis casos se enviaron como nódulos, de los cuales cuatro fueron negativos y en dos de ellos se aisló Corynebacterium sp. La inhabilidad para aislar C. pseudotuberculosis a partir de muestras obtenidas con tórulas de los abscesos pudo deberse a una contaminación de las tórulas, desarrollándose rápidamente contaminantes en las placas, lo que podría haber dificultado el crecimiento de C. pseudotuberculosis o a que se hayan muestreado porciones estériles del absceso, ya que los abscesos de LAC consisten en grandes masas amorfas de material necrótico, en el cual hay relativamente pocos microorganismos, estando éstos distribuidos en racimos (Brown y col 1985).
El total de nódulos afectados en los 81 animales con cultivo positivo a LAC se presenta en el figura 3. El mayor porcentaje de cultivos positivos se obtuvo cuando se enviaron los nódulos linfáticos al laboratorio. Esto difiere de los resultados obtenidos por Stoops y col (1984), quienes aislaron C. pseudotuberculosis del 100% de las muestras de abscesos enviadas a laboratorio. Estos autores transfirieron la muestra del material purulento en forma inmediata a una placa petri que contenía Agar Columbia sangre, suplementado con 5% de sangre desfibrinada. Brown y col (1985) también obtuvieron C. pseudotuberculosis en todos los abscesos de nódulos linfáticos ovinos y caprinos de su estudio, al depositar directamente muestras de material purulento de los abscesos en agar sangre y en aquellos casos en que los intervalos fueron mayores a 48 horas, incubaron la muestras en caldo cerebro corazón por dos horas antes de traspasarlas a las otras placas.
 |
| Figura 3. Porcentaje de nódulos
linfáticos y pulmones afectados (n = 94), en ovinos con cultivo
positivo a LAC.
Percentage of lymph nodes and lungs affected (n = 94), from sheep with positive cultures to CLA. |
Al considerar en conjunto los nódulos linfáticos externos, nuestros hallazgos son similares a los descritos por Ayers (1977) y Lloyd (1994), quienes indican que los principales nódulos linfáticos involucrados son los superficiales (prefemorales y preescapulares), lo cual indicaría que la forma más importante de la transmisión de LAC es la contaminación de lesiones producidas durante la esquila, contaminación que podría producirse desde el medio ambiente o por contacto directo con animales infectados (Nagy 1976).
En Inglaterra y en Arabia Saudita las lesiones por LAC se presentan principalmente en los nódulos linfáticos submandibulares, indicando que la transmisión ocurre a través del contacto del C. pseudotuberculosis con la cabeza y cuello de los animales, probablemente como resultado del estrecho contacto al compartir en comederos, bajo condiciones de crianza intensiva (Binns y col 2002). Scott y col (1997) han sugerido una asociación genética para la ubicación de la lesión, relacionada a la expresión de diferentes antígenos leucocitarios de histocompatibilidad.
De los 81 animales con cultivos positivos a LAC se recolectaron 94 abscesos. Los nódulos linfáticos individualmente más afectados fueron los mediastínicos, de éstos, en 26 casos estaban sólo ellos afectados y en los restantes casos estaban asociados a abscesos en otros nódulos linfáticos y/o pulmón. Las adherencias entre los nódulos linfáticos mediastínicos y otros tejidos, especialmente pulmón, fueron frecuentes. Al considerar el total de abscesos encontrados en los nódulos linfáticos (figura 3), los hallazgos de este trabajo concuerdan, en parte, con las observaciones de Maddy (1953) en Estados Unidos, quien reportó una mayor presentación en los nódulos linfáticos mediastínicos (81%), pulmonares (79%), preescapulares (24%) y prefemorales (15%). Otros investigadores también han encontrado una mayor prevalencia de abscesos en los nódulos linfáticos mediastinales, además de una alta presentación de lesiones en los nódulos linfáticos retrofaríngeos (Sheikh-Omar y Shah 1984). Esta alta prevalencia de lesiones internas, sin lesiones en nódulos linfáticos externos, mantiene las dudas sobre la forma de transmisión de LAC entre ovinos. Experimentalmente, las lesiones torácicas han sido producidas por inyección de cultivos en forma intradérmica o subcutánea y hematógena, originando abscesos en el parénquima pulmonar o nódulos linfáticos torácicos (Nair y Robertson 1974), pero también es posible que el organismo llegue al pulmón directamente a través de inhalación, aunque la inoculación intranasal de cultivos no ha sido satisfactoria para producir al enfermedad en forma experimental (Brown y col 1985, Brown y Olander 1987). Sin embargo, Pepin y col (1994) indican que existe suficiente evidencia que sustentaría que, al menos en Australia, los abscesos pulmonares tienen un papel importante en la diseminación de la infección por vía aerógena.
Las lesiones torácicas disminuyen la capacidad funcional respiratoria e incrementan la susceptibilidad para enfermedades sistémicas, además limitan la habilidad del animal para hacer frente a factores estresantes del medio ambiente (Stoops y col 1984). La forma visceral de LAC ha sido sugerida como un factor involucrado en el desarrollo del "síndrome de la oveja delgada" (Renshaw y col 1979), el cual provoca pérdidas económicas considerables (Stoops y col 1984).
En base a nuestros resultados podemos concluir que la enfermedad Linfoadenitis Caseosa (LAC) ovina se encuentra presente en el ganado ovino de la XI Región. Que los nódulos linfáticos que presentaron mayor número de lesiones correspondientes a LAC fueron los de la canal externa; sin embargo, al considerarlos en forma individual los más afectados fueron los mediastínicos. En cuanto a la procedencia de los animales afectados el diseño del estudio no nos permite obtener conclusiones.
REFERENCIAS
Augustine SL, HW Renshaw. 1986. Survival of Corynebacterium pseudotuberculosis in axenic virulent exudate on common barnyard fomites. J Vet Res 47, 713-715.
Ayers JL. 1977. Caseous Lymphadenitis of Goats and Sheep: A Review of Diagnosis, Pathogenesis, and Immunity. JAVMA 171, 1251-1254.
Batey RG. 1986. Pathogenesis of lymphadenitis in sheep and goats. Aus Vet J 63, 269-272.
Binns SH, LE Green, M Bailey. 2002. Postal survey of ovine casous lymphadenitis in the United Kingdom between 1990 and 1999. Vet Rec 150, 263-268.
Brown CC, HJ Olander, SF Alves. 1985. Synergic Hemolysis - Inhibition Titers Associated with Caseous Lymphadenitis in a Slaughterhouse Survey of Goats and Sheep in Northeastern Brazil. Can J Vet Res 51, 46-49.
Brown CC., HJ Olander. 1985. Caseous Lymphadenitis of Goats and Sheep: A Review. Vet Bull 57, 1-11.
Chile, Servicio Agrícola y Ganadero. 1996. Vigilancia Epidemiológica. Boletín Nº 33. Chile.
Chile, Servicio Agrícola y Ganadero. 1997. Vigilancia Epidemiológica. Boletín Nº 34. Chile. 1997.
Gates NL, DO Everson, CV Hulet. 1997. Effects of the Thin Ewe Syndrome on Reproductive Efficiency. JAVMA 171, 1266-1267.
Kuria JK, G Holstad. 1989. A serological investigation of Corynebacterium pseudotuberculosis infection in sheep flocks in Southern Norway. Acta vet Scand 30, 107-108.
Literak I, B Skalka, R Rychla. 1994. Danger for sheep farming. Caseous lymphadenitis (pseudotuberculosis of sheep also in the Czeck Republic). Veterinarstvi 44, 149-151.
Lloyd S. 1994. Caseous lymphadenitis in sheep and goats. In Practice 16, 24-27.
Maddy K. 1953. Caseous Lymphadenitis in Sheep. JAVMA 122, 257-259.
Middleton MJ, VM Epsten, GG Gregory. 1991. Caseous Lymphadenitis on Flinders Island: prevalence and management surveys. Aus Vet J 68, 311-312.
Montiel RF. 1995. Patologías microscópicas y fallas de procesamiento en ovinos Corriedale. Tesis, Fac. Cs. Veterinarias. Universidad Austral de Chile.
Nair ME, JP Robertson. 1974. Corynebacterium pseudotuberculosis infection of sheep: role of skin lesions and dipping fluids. Aus Vet J 50, 537-542.
Nagy G. 1976. Caseous lymphadenitis in sheep-method of infection. J S Afr Vet Assoc 47, 197-199.
Paton MW, AR Mercy, FC Wilkinson, JJ Gardner, SS Sutherland, TM Ellis. 1988. The Effects of caseous lymphadenitis on wool production and bodyweight in young sheep. Aus Vet J 65: 117-119.
Paton MW, SS Sutherland, IR Rose, RA Hart, AR Mercy, TM Ellis. 1995. The spread of Corynebacterium pseudotuberculosis infection to unvacinated and vaccinated sheep. Aus Vet J 72, 266-269.
Paton MW, IR Rose, RA Hart, SS Sutherland, AR Mercy, TM Ellis. 1995. Post- shearing management affects the seroincidence of Corynebacterium pseudotuberculosis infection in sheep flocks. Prev Vet Med 26, 275-284.
Paton MW. 1997. The epidemiology of Caseous Lymphadenitis in Australia and observations on other production systems. En: Proceedings of 101st Meeting of the US Animal Health Association, October 18-24, Louisville, KY, USA.
Paton MW, NB Buller, IR Rose, TM Tellis. 2002. Effect of the interval between shearing and dipping on the spread of Corynebacterium pseudotuberculosis infection in sheep. Aust Vet J 80, 494-496.
Pepin M, M Paton, ALM Hodgson. 1994. Pathogenesis and epidemiology of Corynebacterium pseudotuberculosis infection in sheep. Current Topics Vet Res 1, 63-82.
Renshaw HW, VP Graff, NL Gates. 1979. Visceral Caseous Lymphadenitis in Thin Ewe Syndrome: Isolation of Corynebacterium, Staphylococcus, and Moraxella spp from Internal Abscesses in Emaciated Ewes. Am J Vet Res 40, 1110-1114.
Scott PR, DDS Collie, LH Hume. 1997. Caseous lymphadenitis in a commercial ram stud in Scotland. Vet Rec 141, 548-549.
Sherman DM, RA Robinson. 1983. Clinical Examination of Sheep and Goats. Vet Clin NA: Large Anim Pract 5, 409-426.
Sheikh-Omar AR, M Shah. 1984. Caseous lymphadenitis in sheep imported from Australia for slaughter in Malaysia. Aus Vet J 61, 410.
Stoops SG, HW Renshaw, JP Thilsted. 1984. Ovine caseous lymphadenitis: Disease prevalence, lesion distribution, and thoracic manifestations in a population of nature culled sheep from Western United States. Am J Vet Res 45, 557-561.
Williamson LH. 2001. Caseous lymphadenitis in small ruminants. En Update on Small Ruminant Medicine, Vet Clin NA: Food Anim Pract 17, 359-371.
Aceptado: 26.04.2005.
# Este trabajo fue financiado por el proyecto "Apoyo al Diagnóstico y Control de Enfermedades Exóticas del Ovino en la XI Región de Aysén", Fondo para el Mejoramiento Sanitario del SAG y FUNDA.
* Fax: 56-63-221354. ntadich@uach.cl. Casilla 567, Valdivia, Chile.
